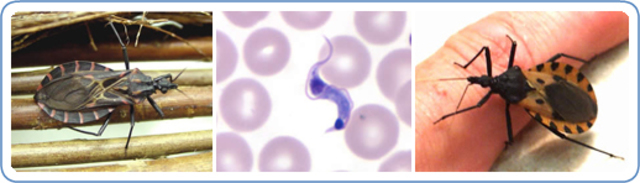
Carlos Chagas

Capítulo II, Historia de la Parasitología. Cordero del Campillo, M, Rojo Vázquez, F. A.
By Josselyn719
-
Fundó el Instituto Nacional de Parasitología del Consejo Superior de Investigaciones Científicas (CSIC) que lleva su nombre (hoy Instituto de Parasitología y Biomedicina <<López Neyra>>)
-
Descubrió el Trypanosoma cruzi, agente etiológico de la enfermedad de Chagas así como el transmisor y su cuadro clínico.
-
Encontró que el díptero Aëdes aegypti es el transmisor de la fiebre amarilla urbana
-
Descubrió el papel de los mosquitos en la transmisión de la malaria.
-
Descubrió los plasmodios
-
Identificó a la Entamoeba histolytica en la materia fecal de una persona enferma de diarrea y demostró la patogenicidad de este protozoo al infectar a un perro.
-
Demostraron la transimisión de un protozoo por artrópodos, quienes probaron que Babesia bigemina era transmitida por la garrapata Boophilus annulatus.
-
Hace una descripción correcta del primer protozoo reconocido como parásito y que fue Balantidium coli.
-
Publica el papel de los mosquitos en la transmisión del paludismo.
-
Estudió paásitos de mamíferos, aves, peces moluscos y crustáceos. Incuyó también, descripciones de los órganos reproductores de Ascaris lumbricoides y sus huevecillos.
-
Describió bacterias, protozoos y microorganismos, con el invento del microoscopio en el que realizó observaciones de materia fecal, saliva, etc.
-
Describe infecciones larvarias causadas por el Cisticerco
-
Describe el parásito Fasciola Hepática en los conductos biliares de los borregos.
-
Se describe a la Taena Saginata
-
Funda la Escuela de Parasitología Española
A list shows items. A timeline shows sequence.
Use Timetoast to make dates, milestones, and turning points easier to understand in a clear visual format. Timetoast is a timeline maker for work, school, research, and stories.